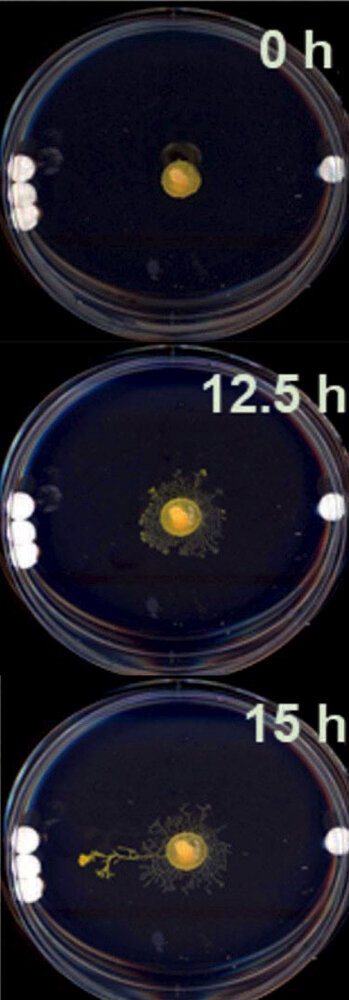
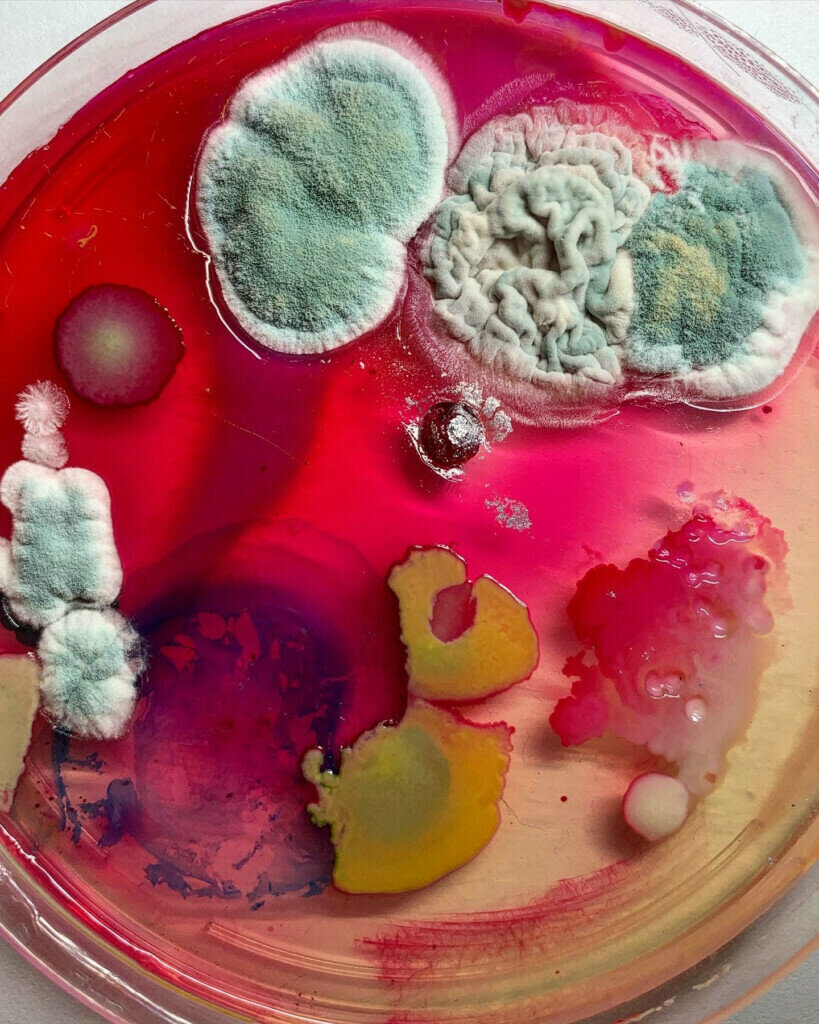

Generative Art
DM3008
S2 AY2024
S2 AY2024
Syllabus
ntu S1 AY2526 | DM3008 | Generative art
(under 'Information')
Submissions
Upload your outcomes here
READINGS
Download the readings here
Schedule
Week 1
ntu S1 AY2526 | DM3008 | Generative art
August 11
Introduction to GenArt
Week 2
August 18
Autonomous Systems in Art
Exercise 1 (5%)
Week 3
August 25
Coding in Art
Exercise 2 (5%)
Week 4
September 1
Natural Intelligence in Art
Live Performance in GenArt
Week 5
September 8
AI in Art
Exercise 3 (5%)
Week 6
September 15
Creating Generative Art
Week 7
September 22
Individual Presentations
Presentations (15%)
Schedule
ntu S1 AY2526 | DM3008 | Generative art
September 29
Recess Week
Week 8
October 6
Intro to TouchDesigner 1
Week 9
October 13
Intro to TouchDesigner 2
Week 10
October 20
Deepavali (no class)
Week 11
October 27
Working session: Final Project
Final Project (40%)
Week 12
November 3
Working session: Final Project
Week 13
November 10
Final Project Presentations
Exercise 4 (5%)
Exercise 5 (5%)
Week 14
November 17
Submission Deadline (no class)
Introductions
What does generative mean to you?
What are your interests in generative art?
Survey of everyone's knowledge and skills in softwares or hardwares
ntu S1 AY2526 | DM3008 | Generative art
10 min

ntu S1 AY2526 | DM3008 | Generative art
About Jo
Jo Ho (b. 1991, Singapore) is an artist working with emerging technology to explore human perceptions and imaginations of our rapidly advancing computational tools. She often questions the conception that digital assets are immaterial by exploring what she calls ‘digital corporeality’, the bridging of the digital with the corporeal.
Jo works with interactive installations, moving images, projection mapping, digital paintings using data and machine-learned graphics as material, and virtual experiences created with game engines. Recently, she has been incorporating performance in her practice to further extend emerging digital tools into live- and body-based work.
ntu S1 AY2526 | DM3008 | Generative art
ntu S1 AY2024 | DM3008 | Generative art
NONOTAK - Shiro
2016

Week 4 | Live Performance & GenArt
Relationship between Humans and Digital Technology
Value and Presentation of Digital Art
Speculative Futures
Physicality vs. Digitality
ntu S1 AY2526 | DM3008 | Generative art
ENZYME 1.2 (2023) AT ARTSCIENCE MUSEUM, SINGAPORE
ntu S1 AY2526 | DM3008 | Generative art
SORRY FOR THE TECHNICAL DIFFICULTIES (2024) AT ART OUTREACH, SINGAPORE




ntu S1 AY2526 | DM3008 | Generative art
Machinations of a Godless Mind (2023) AT HATCH ART PROJECT, SINGAPORE
ntu S1 AY2526 | DM3008 | Generative art
My Desire to Consume (2022) at Grey Projects, Singapore
ntu S1 AY2526 | DM3008 | Generative art
A DEVELOPING SLATE (2024) AT AMEZ YAVUZ GALLERY, SINGAPORE




ntu S1 AY2526 | DM3008 | Generative art
disassemble (2021-2022)


ntu S1 AY2526 | DM3008 | Generative art
(RE)ROOTING (2021) AT NATIONAL GALLERY SINGAPORE
ntu S1 AY2526 | DM3008 | Generative art
📶👽🧠☄️ Ҽ-ՑɾɾɾɾɾS 🔗🌐💦 ÌՂ ƑՄɾɾɾɾS 😈💅✨(2022) AT ESPLANADE, SINGAPORE
ntu S1 AY2526 | DM3008 | Generative art
EXQUISITE MONSTER (2022) AT GOETHE INSTITUTE, SINGAPORE
ntu S1 AY2526 | DM3008 | Generative art
EXQUISITE MONSTER (2024) AT STARCH.SG, SINGAPORE
ntu S1 AY2526 | DM3008 | Generative art
BUSSY TEMPLE (2023) AT T:>WORKS, SINGAPORE


ntu S1 AY2526 | DM3008 | Generative art
1
What is generative art?
REFIK ANADOL - Machine Hallucinations
MoMA, 2022 - 2024
ntu S1 AY2526 | DM3008 | Generative art
WEEK 1 | WHAT IS GENERATIVE ART?
ntu S1 AY2526 | DM3008 | Generative art
WEEK 1 | WHAT IS GENERATIVE ART?
REFIK ANADOL




ntu S1 AY2526 | DM3008 | Generative art
WEEK 1 | WHAT IS GENERATIVE ART?
TEAMLAB - Universe of Water Particles on a Rock Where People Gather
2018
ntu S1 AY2526 | DM3008 | Generative art
WEEK 1 | WHAT IS GENERATIVE ART?
ntu S1 AY2526 | DM3008 | Generative art
WEEK 1 | WHAT IS GENERATIVE ART?
TEAMLAB




ntu S1 AY2526 | DM3008 | Generative art
WEEK 1 | WHAT IS GENERATIVE ART?
ntu S1 AY2526 | DM3008 | Generative art
WEEK 1 | WHAT IS GENERATIVE ART?
DAVID OREILLY - EYE OF THE DReaM
2018
ntu S1 AY2526 | DM3008 | Generative art
WEEK 1 | WHAT IS GENERATIVE ART?
ntu S1 AY2526 | DM3008 | Generative art
WEEK 1 | WHAT IS GENERATIVE ART?
DAVID OREILLY



ntu S1 AY2526 | DM3008 | Generative art
WEEK 1 | WHAT IS GENERATIVE ART?
SOL LEWITT - INSTRUCTIONAL DRAWINGS
1975
ntu S1 AY2526 | DM3008 | Generative art
WEEK 1 | WHAT IS GENERATIVE ART?
ntu S1 AY2526 | DM3008 | Generative art
WEEK 1 | WHAT IS GENERATIVE ART?
SOL LEWITT




ntu S1 AY2526 | DM3008 | Generative art
WEEK 1 | WHAT IS GENERATIVE ART?
nam jun paik - tv buddha
1974 / 2002
ntu S1 AY2526 | DM3008 | Generative art
WEEK 1 | WHAT IS GENERATIVE ART?
ntu S1 AY2526 | DM3008 | Generative art
WEEK 1 | WHAT IS GENERATIVE ART?
nam jun paik




ntu S1 AY2526 | DM3008 | Generative art
WEEK 1 | WHAT IS GENERATIVE ART?
JOhn cage - 4'33"
1952

ntu S1 AY2526 | DM3008 | Generative art
WEEK 1 | WHAT IS GENERATIVE ART?
ntu S1 AY2526 | DM3008 | Generative art
WEEK 1 | WHAT IS GENERATIVE ART?
JOhn cage

ntu S1 AY2526 | DM3008 | Generative art
WEEK 1 | WHAT IS GENERATIVE ART?
JOhn cage




ntu S1 AY2526 | DM3008 | Generative art
WEEK 1 | WHAT IS GENERATIVE ART?


ZACH LIEBERMAN AND HIS CODING EXPERIMENTS
ntu S1 AY2526 | DM3008 | Generative art
WEEK 1 | WHAT IS GENERATIVE ART?
ntu S1 AY2526 | DM3008 | Generative art
WEEK 1 | WHAT IS GENERATIVE ART?
ZACH LIEBERMAN AND HIS CODING EXPERIMENTS


ntu S1 AY2526 | DM3008 | Generative art
WEEK 1 | WHAT IS GENERATIVE ART?
CASEY REAS




ntu S1 AY2526 | DM3008 | Generative art
WEEK 1 | WHAT IS GENERATIVE ART?
ntu S1 AY2526 | DM3008 | Generative art
WEEK 1 | WHAT IS GENERATIVE ART?
Sougwen Chung - Sougwen Chung, Drawing with D.O.U.G. Performance
2016
ntu S1 AY2526 | DM3008 | Generative art
WEEK 1 | WHAT IS GENERATIVE ART?
ntu S1 AY2526 | DM3008 | Generative art
WEEK 1 | WHAT IS GENERATIVE ART?
Sougwen Chung




ntu S1 AY2526 | DM3008 | Generative art
WEEK 1 | WHAT IS GENERATIVE ART?
HOLLY HERNDON - SPAWN
2020
ntu S1 AY2526 | DM3008 | Generative art
WEEK 1 | WHAT IS GENERATIVE ART?
ntu S1 AY2526 | DM3008 | Generative art
WEEK 1 | WHAT IS GENERATIVE ART?
HOLLY HERNDON



ntu S1 AY2526 | DM3008 | Generative art
WEEK 1 | WHAT IS GENERATIVE ART?
ntu S1 AY2526 | DM3008 | Generative art
WEEK 1 | WHAT IS GENERATIVE ART?
WHAt is generative art?
Breakaway into smaller groups.
Write down your thoughts.
Discuss amongst each other:
‣ Which projects were you most drawn to?
‣ What were some similar characteristics?
‣ How were the projects 'generative'?
‣ What disciplines does GenArt span?
‣ What kind of soft/hardware did you see?
20 min
ntu S1 AY2526 | DM3008 | Generative art
WEEK 1 | WHAT IS GENERATIVE ART?
GENERATIVE ASSOCIATIONS
Let's share what you found in your discussions.
But first: Let's do a word association exercise. Jo will start first, and whoever has a similar word sounds it out. Don't worry about interrupting each other.
5 min
ntu S1 AY2526 | DM3008 | Generative art
WEEK 1 | WHAT IS GENERATIVE ART?
WHAt is generative art?
Let's share what you found in your discussions.
‣ Which projects were you most drawn to?
‣ What were some similar characteristics?
‣ How were the projects 'generative'?
‣ What disciplines does GenArt span?
‣ What kind of soft/hardware did you see?
20 min
ntu S1 AY2526 | DM3008 | Generative art
WEEK 1 | WHAT IS GENERATIVE ART?
Generative art refers to any art practice where the artist uses a system, such as a set of natural language rules, a computer program, a machine, or other procedural invention, which is set into motion with some degree of autonomy contributing to or resulting in a completed work of art.
Philip Galanter, artist and professor at Texas A&M University, from his 2003 paper “What Is Generative Art? Complexity Theory as a Context for Art Theory”
ntu S1 AY2526 | DM3008 | Generative art
WEEK 1 | WHAT IS GENERATIVE ART?
An algorithmic way of creating an aesthetic.
A collaboration between an artist and an autonomous system.
An exercise in extracting unpredictable results from perfectly deterministic processes.
A quest for that sweet spot between order and chaos.
A fresh, fun approach to coding
MATT PEARSON, an author, artist and programmer from his book
"Generative Art: A Practical Guide Using Processing"
FOR WEEK 2
Some questions to think about:
‣ How do the authors challenge or support your understanding of "creations" from a machine?
‣ Which of these resonates most with you and why? How does it relate to you?
‣ How do the authors define "good" generative art? Do you agree?
Read 'Ten Questions Concerning Generative Computer Art'
By Jon Mccormack, Oliver Bown, Alan Dorin, Jonathan McCabe, Gordon Monro and Mitchell Whitelaw
2
AUTONOMOUS SYSTEMS in art
ntu S1 AY2526 | DM3008 | Generative art
DISCUSSION ON READING
15 min
‣ How do the authors challenge or support your understanding of "creations" from a machine?
‣ Which of the questions are you most curious about and why?
‣ How do the authors define "good" generative art? Do you agree?
Read 'Ten Questions Concerning Generative Computer Art'
By Jon Mccormack, Oliver Bown, Alan Dorin, Jonathan McCabe, Gordon Monro and Mitchell Whitelaw
WEEK 2 | Autonomous Systems In art
ntu S1 AY2526 | DM3008 | Generative art
What does generative mean?
Randomly generated
Unpredictable
Using uncertainty
Unrepeatable
Unique
Varying outcomes
Autonomous systems
Process-driven
Geometric/abstract
Procedural Systematic
Artists set the rules
Recipes
Time, environment
Building relationships
Changing results
Viewer interaction
WEEK 2 | Autonomous Systems In art
ntu S1 AY2526 | DM3008 | Generative art
elements of generativity
Datasets
Iterations
Algorithms
Repetition
Randomness
Automation
Controlled Chaos
Interactivity
Commentary
Autonomous
Algorithms
Visuals
Rules
Time
WEEK 2 | Autonomous Systems In art
ntu S1 AY2526 | DM3008 | Generative art
Disciplines that span genart
Game design
Manual/analog
Line art
Robotics
Visual Art
Sonic art/Music
Computer Science
Engineering
Math
Sciences
Graphic Design
Architecture
Painting
Installation
Image-making
Video Art
WEEK 2 | Autonomous Systems In art
ntu S1 AY2526 | DM3008 | Generative art
hardware/software
Computers
3D Printers
Digital Screens
Projector
Robots
Cameras
Mics
Sensors
Speakers
Environment
Nature
Paint / Trad Media
Cameras
P5js
TouchDesigner
Unity
WEEK 2 | Autonomous Systems In art
ntu S1 AY2526 | DM3008 | Generative art
Aesthetic styles of genart
Animated
Minimalistic
Humor
Abstract
Interactivity
Natural
Geometric
Data-driven
Painting
Games, programming
Point clouds
Experimental
Surrealism
Organic
Avatars
WEEK 2 | Autonomous Systems In art
ntu S1 AY2526 | DM3008 | Generative art
Coined in 1965 by the German philosopher Max Bense, the term generative art describes works based on an algorithmic code or a mathematical formula. Generative art is made through a set of rules that automates the output where there is usually randomness embedded in the algorithm.
WEEK 2 | Autonomous Systems In art
ntu S1 AY2526 | DM3008 | Generative art
"Bense’s theory of generative art assumes not only that aesthetic experience can be measured but that it can also be rationally and predictably produced.
WEEK 2 | Autonomous Systems In art
ntu S1 AY2024 | DM3008 | Generative art
WEEK 2 | autonomous systems in art
INPUT
OUTPUT
UNPREDICTABLE OUTCOMES
UNPREDICTABLE OUTCOMES
PREDICTABLE OUTCOMES
ntu S1 AY2024 | DM3008 | Generative art
WEEK 2 | autonomous systems in art
INPUT
OUTPUT
Sweet Spot
ntu S1 AY2526 | DM3008 | Generative art
WEEK 1 | WHAT IS GENERATIVE ART?
questions to keep in mind
‣ How does the artist approach technology?
‣ What is the artist investigating when working with technology?
‣ How do you think the artist addresses the viewer in their work?
ntu S1 AY2024 | DM3008 | Generative art
marcel duchamp - Fountain
1917

WEEK 2 | autonomous systems in art
ntu S1 AY2024 | DM3008 | Generative art
marcel duchamp
(1887 - 1968)

WEEK 2 | autonomous systems in art
ntu S1 AY2024 | DM3008 | Generative art
By World War I, he had rejected the work of many of his fellow artists as “retinal” art, intended only to please the eye. Instead, Duchamp wanted, he said, “to put art back in the service of the mind.”
WEEK 2 | autonomous systems in art
ntu S1 AY2024 | DM3008 | Generative art
marcel duchamp - 3 STANDARD Stoppages
1913-1914

WEEK 2 | autonomous systems in art
ntu S1 AY2024 | DM3008 | Generative art
marcel duchamp - 3 STANDARD Stoppages
1913-1914

The Idea of the Fabrication
–If a threadone meter longfalls straight from a height of one meter on to a horizontal plane twisting as it pleases and creates a new image of the unit of length
— 3 examples obtained more or less similar conditions considered in their relation to one another they are an approximate reconstitution of the unit of length
The 3 standard stoppages are the meter diminished.
WEEK 2 | autonomous systems in art
ntu S1 AY2024 | DM3008 | Generative art
(Katherine Kuh, The Artist's Voice: Talks with Seventeen Artists, New York 1962, p.81.)
tate.org.uk
[link]
Asked what he considered to be his most important work, he replied: 'As far as date is concerned I'd say the Three Stoppages of 1913. That was when I really tapped the mainspring of my future. In itself it was not an important work of art, but for me it opened the way - the way to escape from those traditional methods of expression long associated with art. For me the Three Stoppages was a first gesture liberating me from the past.'
WEEK 2 | autonomous systems in art
ntu S1 AY2024 | DM3008 | Generative art
marcel duchamp - bicycle wheel
1951 (3rd version), 1913 (lost)

WEEK 2 | autonomous systems in art
ntu S1 AY2024 | DM3008 | Generative art
artists from the dada movement (1916)

WEEK 2 | autonomous systems in art
ntu S1 AY2024 | DM3008 | Generative art
Reacting against the rise of capitalist culture, the war, and the concurrent degradation of art, artists in the early 1910s began to explore new art, or “anti-art”, as described by Marcel Duchamp. They wanted to contemplate the definition of art, and to do so they experimented with the laws of chance and with the found object.
Theirs was an art form underpinned by humor and clever turns, but at its very foundation, the Dadaists were asking a very serious question about the role of art in the modern age.
WEEK 2 | autonomous systems in art
ntu S1 AY2024 | DM3008 | Generative art
First dada gallery opening
1920

WEEK 2 | autonomous systems in art
ntu S1 AY2024 | DM3008 | Generative art
exquisite corpse (invented by surrealists)
as early as 1918

WEEK 2 | autonomous systems in art
ntu S1 AY2024 | DM3008 | Generative art
Cadavre Exquis with Esteban Francés, Remedios Varo, Oscar Domínguez, Marcel JeaN
1935

WEEK 2 | autonomous systems in art
ntu S1 AY2024 | DM3008 | Generative art


WEEK 2 | autonomous systems in art
ntu S1 AY2024 | DM3008 | Generative art
1945
WEEK 2 | autonomous systems in art
ntu S1 AY2024 | DM3008 | Generative art
THE ENAIC at the university of pennsylvania
1945

WEEK 2 | autonomous systems in art
ntu S1 AY2024 | DM3008 | Generative art
first modern computer in the world, using electronic technology

WEEK 2 | autonomous systems in art
ntu S1 AY2024 | DM3008 | Generative art
1970s
WEEK 2 | autonomous systems in art
ntu S1 AY2024 | DM3008 | Generative art
LINC (mit, 1962)


Datapoint 2200 (IBM, 1970)

Micral N (R2E, 1973)

Xerox Alto (1973)
WEEK 2 | autonomous systems in art
ntu S1 AY2024 | DM3008 | Generative art
from left to right: the Commodore PET 2001, the Apple II, and the Tandy/Radio Shack TRS-80 Model 1
1976

WEEK 2 | autonomous systems in art
ntu S1 AY2024 | DM3008 | Generative art
1960s
WEEK 2 | autonomous systems in art
ntu S1 AY2024 | DM3008 | Generative art
WEEK 2 | autonomous systems in art
ntu S1 AY2024 | DM3008 | Generative art
Audio casette
Video game console
The computer mouse
Telephone network
Computer networking
Satellite communications
Lasers
Optical fibers
WEEK 2 | autonomous systems in art
ntu S1 AY2024 | DM3008 | Generative art

EXPErIMENTs IN ART AND TECHNOLOGY
1966
WEEK 2 | autonomous systems in art
ntu S1 AY2024 | DM3008 | Generative art
EXPErIMENTs IN ART AND TECHNOLOGY
1966

WEEK 2 | autonomous systems in art
ntu S1 AY2024 | DM3008 | Generative art
EXPErIMENTs IN ART AND TECHNOLOGY
1966
WEEK 2 | autonomous systems in art
Robert Rauschenberg
Robert Whitman
Bill Klüver
Fred Waldhauer
Robert Breer
John Cage
Chandralekha
Lucinda Childs
Öyvind Fahlström
Deborah Hay
Marcos Marin
Fujiko Nakaya
Dashrath Patel
Steve Paxton
Yvonne Rainer
Vikram Sarabhai
Xanti Schawinsky
David Tudor
Andy Warhol
Beatie Wolfe
Nam Jun Paik
ntu S1 AY2024 | DM3008 | Generative art
BELL LABS (NEW JERSEY)
1966




WEEK 2 | autonomous systems in art
ntu S1 AY2024 | DM3008 | Generative art
The sprawling Murray Hill campus on Mountain Avenue was a bustling center for innovation in suburban Union County for decades. It served as the headquarters for a 90-year-old company whose researchers helped earn 10 Nobel Prizes, five Turing Awards for computer science breakthroughs and more than 20,000 patents.
At its height, Bell Labs employed nearly 15,000 people in New Jersey, including some of the world’s top scientists and innovators.
WEEK 2 | autonomous systems in art

ntu S1 AY2024 | DM3008 | Generative art
WEEK 2 | autonomous systems in art
ntu S1 AY2024 | DM3008 | Generative art
9 Evenings: Theatre & Engineering by E.A.T. & BELL LABS
Performance DOCUMENTATION
WEEK 2 | autonomous systems in art
Robert Rauschenberg - Open Score
1966
ntu S1 AY2024 | DM3008 | Generative art
WEEK 2 | autonomous systems in art
JOHN CAGE - VARIATIONS VII
1966
ntu S1 AY2024 | DM3008 | Generative art
WEEK 2 | autonomous systems in art
DEBORAH HAY - SOLO
1966
ntu S1 AY2024 | DM3008 | Generative art
WEEK 2 | autonomous systems in art
ARTIST Julie Martin ON E.A.T.
2013
ntu S1 AY2024 | DM3008 | Generative art
WEEK 2 | autonomous systems in art
ntu S1 AY2024 | DM3008 | Generative art
nam jun paik

WEEK 2 | autonomous systems in art
ntu S1 AY2024 | DM3008 | Generative art
nam jun paik - tv buddha
1974 / 2002
WEEK 2 | autonomous systems in art
ntu S1 AY2024 | DM3008 | Generative art
nam jun paik - magnet tv
1965

WEEK 2 | autonomous systems in art
ntu S1 AY2024 | DM3008 | Generative art
nam jun paik - TV CROWN
1965

WEEK 2 | autonomous systems in art
ntu S1 AY2024 | DM3008 | Generative art
nam jun paik - TV CROWN
1965
WEEK 2 | autonomous systems in art
ntu S1 AY2024 | DM3008 | Generative art
Conserving and Exhibiting the Works of Nam June Paik: Joanna Phillips
2013
WEEK 2 | autonomous systems in art
ntu S1 AY2024 | DM3008 | Generative art
"The Wobbulator"
2010
WEEK 2 | autonomous systems in art
ntu S1 AY2024 | DM3008 | Generative art
WEEK 2 | autonomous systems in art
p5.js Editor
An introduction to p5.js
ntu S1 AY2024 | DM3008 | Generative art
WEEK 2 | autonomous systems in art
p5.js Editor
‣ Functions help structure your code.
‣ Code is executed from top to bottom (order matters).
‣ Curly braces {}
help enclose code in a function.
‣ Don't for get your camelCase.
‣ American spelling when calling for built-in variables and functions.
‣ Arithmetic rules here apply
Important things to note
ntu S1 AY2024 | DM3008 | Generative art
WEEK 2 | autonomous systems in art
p5.js Editor
‣ Arithmetic rules here apply
Important things to note
+ addition
- subtraction
* multiplication
/ division
ctrl + /
to comment Windows
cmd + /
to comment on Mac
console.log()
to talk to the JS Console
Colors are either in RGB (255, 255, 255)
or in hexadecimal ('#000000')
.
ntu S1 AY2024 | DM3008 | Generative art
WEEK 2 | autonomous systems in art
p5.js Editor
Important things to note

ntu S1 AY2024 | DM3008 | Generative art
WEEK 2 | autonomous systems in art
Demo 1
‣ p5.js reference [link]
‣ 2D Primitives [ellipse / line / rect]
‣ Styling [fill / noFill / stroke / strokeWeight / noStroke]
Let's begin with simple shapes and styling
ntu S1 AY2024 | DM3008 | Generative art
WEEK 2 | autonomous systems in art
Demo 2
‣ p5.js reference [link]
‣ Randomness, values between a range [random]
‣ Ever increasing value based on when the sketch was started [frameCount]
‣ Creating simple conditions based on in-built functions like mousePresssed / keyPressed
Let's begin with simple animation
ntu S1 AY2024 | DM3008 | Generative art
WEEK 2 | autonomous systems in art
Exercise 1
‣ Open and duplicate each of the code listed on the right.
‣ Experiment with it. How else could you transform the outcome?
‣ Is there anything you do not recognize? Variables or functions? Search on the p5.js reference to understand more.
Experiment with already created code
40 min
ntu S1 AY2024 | DM3008 | Generative art
WEEK 2 | autonomous systems in art
Exercise 1
Experiment with already created code
ntu S1 AY2024 | DM3008 | Generative art
WEEK 2 | autonomous systems in art
References
FOR WEEK 3
Some questions to think about:
‣ How does Pearson differ in his definition of Generative Art from Galanter?
‣ What example or idea stood out to you?
‣ How could you apply Pearson's way of thinking about your own creative process?
By Matt Pearson, forward by Marius Watz
CODING in art
3
DISCUSSION ON READING
15 min
Some questions to think about:
‣ How does Pearson differ in his definition of Generative Art from Galanter?
‣ What example or idea stood out to you?
‣ How could you apply Pearson's way of thinking about your own creative process?
By Matt Pearson, forward by Marius Watz
ntu S1 AY2526 | DM3008 | Generative art
WEEK 3 | Coding In art
INDIVIDUAL ACTIVITY
On a sheet of paper:
‣ Place 25 points at random. These dots should be evenly distributed.
‣ All of the points should be connected by straight lines.
Drawing #118
By Sol Lewitt
ntu S1 AY2526 | DM3008 | Generative art
WEEK 3 | Coding In art
Draw as you interpret the instructions. There is no right or wrong way!
5 min
sol lewitt - drawing #118
1971

ntu S1 AY2526 | DM3008 | Generative art
WEEK 3 | Coding In art
sol lewitt - drawing #118
1971



ntu S1 AY2526 | DM3008 | Generative art
WEEK 3 | Coding In art
SOL LEWITT's instructional Drawings
1968 - 2007
LeWitt himself observed in 1971 that "each person draws a line differently and each person understands words differently".
The variations in the pressure and speed of the crayon line, its darkness and breadth, the abruptness with which lines end and the confidence with which they meet, will always depend on who's doing the drawing. LeWitt continued: "Neither lines nor words are ideas, they are the means by which ideas are conveyed."
[link to text]
ntu S1 AY2526 | DM3008 | Generative art
WEEK 3 | Coding In art
THE ENAIC at the university of pennsylvania
1945

ntu S1 AY2526 | DM3008 | Generative art
WEEK 3 | Coding In art
from left to right: the Commodore PET 2001, the Apple II, and the Tandy/Radio Shack TRS-80 Model 1
1976

ntu S1 AY2526 | DM3008 | Generative art
WEEK 3 | Coding In art
Early computer art generally refers to computer art made from the 1950s through the 1980s, before personal computers were widely available and used. Much of this art was created by engineers and scientists, as computing resources were accessible only in university and research laboratories.
EARLY COMPUTER ART
ntu S1 AY2526 | DM3008 | Generative art
WEEK 3 | Coding In art




frieder nake
Random Polygonal Train
1965
Vera Molnar
100 Trapezes
1976
manfred mohr
P-197 J
1979
george nees
Computergrafik Computerplastik
1970
ntu S1 AY2526 | DM3008 | Generative art
WEEK 3 | Coding In art
Jean Tinguely
1925 - 1991


ntu S1 AY2526 | DM3008 | Generative art
WEEK 3 | Coding In art
Jean Tinguely - Méta-Matic no 17
1959


ntu S1 AY2526 | DM3008 | Generative art
WEEK 3 | Coding In art
Jean Tinguely - Méta-Matic series
1955-1959



ntu S1 AY2526 | DM3008 | Generative art
WEEK 3 | Coding In art
Graphomat z64
1961


ntu S1 AY2526 | DM3008 | Generative art
WEEK 3 | Coding In art
calcomp 745 flatbed plotter
1972

ntu S1 AY2526 | DM3008 | Generative art
WEEK 3 | Coding In art
modern day plotter

ntu S1 AY2526 | DM3008 | Generative art
WEEK 3 | Coding In art
axidraw - modern day pen plotter

ntu S1 AY2526 | DM3008 | Generative art
WEEK 3 | Coding In art
frieder nake - random polygon
1963

ntu S1 AY2526 | DM3008 | Generative art
WEEK 3 | Coding In art
frieder nake - 13/9/65 Nr. 2 (homage to paul klee)
1965

ntu S1 AY2526 | DM3008 | Generative art
WEEK 3 | Coding In art
frieder nake - 02/09/1965 (boxes with rectangular hatchings nr. 6)
1965

ntu S1 AY2526 | DM3008 | Generative art
WEEK 3 | Coding In art
frieder nake - matrizenmultiplikation serie 29
1967

ntu S1 AY2526 | DM3008 | Generative art
WEEK 3 | Coding In art
manfred mohr - p021-g
1970

ntu S1 AY2526 | DM3008 | Generative art
WEEK 3 | Coding In art
manfred mohr - p031b
1970

ntu S1 AY2526 | DM3008 | Generative art
WEEK 3 | Coding In art
manfred mohr - p-100, combinatorial framework of the ordinal 15
1972

ntu S1 AY2526 | DM3008 | Generative art
WEEK 3 | Coding In art
manfred mohr - p-135a
1973

ntu S1 AY2526 | DM3008 | Generative art
WEEK 3 | Coding In art
manfred mohr - p-197-f
1977

ntu S1 AY2526 | DM3008 | Generative art
WEEK 3 | Coding In art
vera molnár - interruptions
1969

ntu S1 AY2526 | DM3008 | Generative art
WEEK 3 | Coding In art
vera molnár - inclinaisons 32
1971

ntu S1 AY2526 | DM3008 | Generative art
WEEK 3 | Coding In art
vera molnár - 22 ((Des)ordres)
1974

ntu S1 AY2526 | DM3008 | Generative art
WEEK 3 | Coding In art
vera molnár - molndrian, 74,066/13.30.37
1974

ntu S1 AY2526 | DM3008 | Generative art
WEEK 3 | Coding In art

ntu S1 AY2526 | DM3008 | Generative art
WEEK 3 | Coding In art
michael noll - computer composition with lines
1965

ntu S1 AY2526 | DM3008 | Generative art
WEEK 3 | Coding In art
michael noll - ninety computer-generated sinusoids with lineraly increasing period
1965

ntu S1 AY2526 | DM3008 | Generative art
WEEK 3 | Coding In art
JOHN WHITNEY - EXPERIMENTS IN MOTION GRAPHICS
1968
ntu S1 AY2526 | DM3008 | Generative art
WEEK 3 | Coding In art
Also known as computer-generated art, and can also include fractal art.
It uses simple algorithms to create art and can be output by a computer display, printed, or drawn using a plotter.
ALGORITHMIC ART
ntu S1 AY2526 | DM3008 | Generative art
WEEK 3 | Coding In art
roman verostko - untitled
1987

ntu S1 AY2526 | DM3008 | Generative art
WEEK 3 | Coding In art
roman verostko - untitled #81
1987

ntu S1 AY2526 | DM3008 | Generative art
WEEK 3 | Coding In art
roman verostko - pathway -- lung shan II
1989

ntu S1 AY2526 | DM3008 | Generative art
WEEK 3 | Coding In art
roman verostko - Derivation of the Laws of the Symbols of Logic From the Laws of the Operations of the Human Mind: An Excerpt From the Writings of George Boole (End piece)
1990

ntu S1 AY2526 | DM3008 | Generative art
WEEK 3 | Coding In art
roman verostko - pathway series
1993

ntu S1 AY2526 | DM3008 | Generative art
WEEK 3 | Coding In art
Jean pierre hebert - olive bark
1990

ntu S1 AY2526 | DM3008 | Generative art
WEEK 3 | Coding In art
Jean pierre hebert - Jambes noires avec moire
1990

ntu S1 AY2526 | DM3008 | Generative art
WEEK 3 | Coding In art
Jean pierre hebert - Esprit Planant Au-Dessus Des Eaux (Spirit Hovering Above Waters)
1991

ntu S1 AY2526 | DM3008 | Generative art
WEEK 3 | Coding In art
Also known as computer-generated art, and can also include fractal art.
It uses simple algorithms to create art and can be output by a computer display, printed, or drawn using a plotter.
CONTEMPORARY EXAMPLES
ntu S1 AY2526 | DM3008 | Generative art
WEEK 3 | Coding In art

ntu S1 AY2526 | DM3008 | Generative art
WEEK 3 | Coding In art
casey reas - process 4
2005

ntu S1 AY2526 | DM3008 | Generative art
WEEK 3 | Coding In art
casey reas - process 13 software
2011

ntu S1 AY2526 | DM3008 | Generative art
WEEK 3 | Coding In art
casey reas - network D (image 2)
2012

ntu S1 AY2526 | DM3008 | Generative art
WEEK 3 | Coding In art
casey reas - pfft!
2014

ntu S1 AY2526 | DM3008 | Generative art
WEEK 3 | Coding In art
ntu S1 AY2526 | DM3008 | Generative art
WEEK 3 | Coding In art
Peter Bauman: At Le Random, we think of generative art history by generation, informing our collection as well as projects like our Generative Art Timeline. We’ve identified eight phases that fit into three very broad generations:
Generation 1: 1950s - 1980s (The Computer Era)
Generation 2: 1990s - 2014 (The Internet Era)
Generation 3: 2015 - today (The On-Chain Era)
Can you talk about how you would group the different generations of digital generative artists?
Casey Reas: I think of the first generation as the “Mainframe Era.” And then I think of the second as the “Studio Era.” When computers went into artist studios, it was a major change and a major shift. The Apple II (1977), Commodore 64 (1982) and Commodore Amiga (1985) all represent enough of a change, moving out of the research labs and into artist studios, that it's a whole other era.
CASEY REAS ON THE HISTORY OF GENERATIVE ART
ntu S1 AY2526 | DM3008 | Generative art
WEEK 3 | Coding In art
tyler hobbs - fragments of vision d
2014

ntu S1 AY2526 | DM3008 | Generative art
WEEK 3 | Coding In art
tyler hobbs - fidenza #374
2021

ntu S1 AY2526 | DM3008 | Generative art
WEEK 3 | Coding In art
tyler hobbs - one one overflow
2022

ntu S1 AY2526 | DM3008 | Generative art
WEEK 3 | Coding In art
Rafaël Rozendaal - permanent distraction
2021

ntu S1 AY2526 | DM3008 | Generative art
WEEK 3 | Coding In art
Rafaël Rozendaal - permanent distraction
2021




ntu S1 AY2526 | DM3008 | Generative art
WEEK 3 | Coding In art
Rafaël Rozendaal - Art and the blockchain
2021

ntu S1 AY2526 | DM3008 | Generative art
WEEK 3 | Coding In art
Rafaël Rozendaal - RANDOM FEAR (WITH MIRRORS)
2021

ntu S1 AY2526 | DM3008 | Generative art
WEEK 3 | Coding In art
Rafaël Rozendaal - complex computational compositions
2016

ntu S1 AY2526 | DM3008 | Generative art
WEEK 3 | Coding In art
Rafaël Rozendaal - Abstract Browsing 16 03 09 A B C (Waze)
2016

ntu S1 AY2526 | DM3008 | Generative art
WEEK 3 | Coding In art
Rafaël Rozendaal - Abstract Browsing 16 10 05 (Google Spreadsheets)
2016

ntu S1 AY2526 | DM3008 | Generative art
WEEK 3 | Coding In art
Rafaël Rozendaal - Abstract Browsing 18 08 01 (Google Spreadsheets)
2018

ntu S1 AY2526 | DM3008 | Generative art
WEEK 3 | Coding In art
zach lieberman - color ribbon study #1
2021

ntu S1 AY2526 | DM3008 | Generative art
WEEK 3 | Coding In art
zach lieberman - block gradient field
2022

ntu S1 AY2526 | DM3008 | Generative art
WEEK 3 | Coding In art
zach lieberman - chrome waves (still)
2023

ntu S1 AY2526 | DM3008 | Generative art
WEEK 3 | Coding In art
zach lieberman - center point circle study
2024

ntu S1 AY2526 | DM3008 | Generative art
WEEK 3 | Coding In art
ntu S1 AY2526 | DM3008 | Generative art
WEEK 3 | Coding In art












ntu S1 AY2526 | DM3008 | Generative art
WEEK 3 | Coding In art
ntu S1 AY2526 | DM3008 | Generative art
CONTEMPORARY ARTISTS USING CODE
WEEK 3 | CODING In art
DISCUSSION
‣ How did each artist use rules or systems differently?
‣ How were the artworks influenced by the technology the artists used?
‣ Which artist's approach inspires you most?
‣ If you had to choose one rule, system or process from what you saw today to experiment with, which would you choose?
Artists who use code to make art
ntu S1 AY2526 | DM3008 | Generative art
WEEK 3 | Coding In art
10 min
p5.js Recap
Covered last week
+ addition
- subtraction
* multiplication
/ division
ctrl + /
to comment Windows
cmd + /
to comment on Mac
console.log()
to talk to the JS Console
Colors are either in RGB
(255, 255, 255)
or in hexadecimal ('#000000')
.
‣ 2D Primitives [ellipse / line / rect]
‣ Styling [fill / noFill / stroke / strokeWeight / noStroke]
‣ In-built variables [mouse X / mouse Y / width / height]
‣ Random values between a range [random(min, max)]
‣ Ever-increasing value [frameCount]
‣ Simple conditions mousePresssed / keyPressed
ntu S1 AY2526 | DM3008 | Generative art
WEEK 3 | Coding In art
DEMO 3
To cover this week
> greater than
< less than
>= greater than or equal to
<= less than or equal to
== equal to
!= not equal to
‣ Comparison operators
+= addition assignmnet
-= subtraction assignment
*= multiplication assignment
/= division assignment
%= remainder assignment
‣ Assignment operators
&& (and) both conditions are true
| | (or) if at least 1 condition is true
‣ Logical operators
ntu S1 AY2526 | DM3008 | Generative art
WEEK 3 | Coding In art
DEMO 3
Conditional Statements
Conditionals in code (if, else if, else) let a program make decisions by running different instructions depending on whether certain conditions are true or false.
ntu S1 AY2526 | DM3008 | Generative art
WEEK 3 | Coding In art
DEMO 3
Conditional Statements
‣ Custom variables [let]
‣ RGB color information [color]
‣ Conditionals [if, else if, else]
10 min
ntu S1 AY2526 | DM3008 | Generative art
WEEK 3 | Coding In art
DEMO 4
Switch Statement
‣ Switch statement [switch] (in conjunction with mousePressed and keyPressed
‣ Switch statement with if()
10 min
ntu S1 AY2526 | DM3008 | Generative art
WEEK 3 | Coding In art
DEMO 5
For Loop [for]
Defining i
for iterations
Defining the maximum value for i
Value added to i
after each iteration
5 min
‣ i++
for regular increments of 1
‣ i+=
for set value of increments
‣ if(i % 2)
for every other element
for (let i = 0; i < 10; i++) {
console.log(i);
}
ntu S1 AY2526 | DM3008 | Generative art
WEEK 3 | Coding In art
DEMO 5
Sine function [sin]
Multiply the wave, changing min/max
Set the speed of the wave
Shift the wave with an offset value
5 min
amplitude * sin(frequency * i) + offset
ntu S1 AY2526 | DM3008 | Generative art
WEEK 3 | Coding In art
Exercise 2
‣ Open and duplicate each of the code listed on the right.
‣ Experiment with it. How else could you transform the outcome?
‣ Is there anything you do not recognize? Variables or functions? Search on the p5.js reference to understand more.
Experiment with already created code
30 min
ntu S1 AY2526 | DM3008 | Generative art
WEEK 3 | Coding In art
Exercise 2
Experiment with already created code
ntu S1 AY2526 | DM3008 | Generative art
WEEK 3 | Coding In art
FOR WEEK 4
Some questions to think about:
‣ What are the expansive disciplines that Galanter defines as part of GenArt?
‣ What is his view on autonomy or rule-based processes in GenArt?
‣ How does he modify or update his previous definition of Generative art from 2003?
By Philip Galanter
4
Live Performance & Generative Art
DISCUSSION ON READING
15 min
ntu S1 AY2526 | DM3008 | Generative art
WEEK 4 | NATURAL INTELLIGENCE In art
Some questions to think about:
‣ What are the expansive disciplines that Galanter defines as part of GenArt?
‣ What is his view on autonomy or rule-based processes in GenArt?
‣ How does he modify or update his previous definition of Generative art from 2003?
By Philip Galanter
404.zero - 8.0.1
2019
ntu S1 AY2526 | DM3008 | Generative art
WEEK 4 | Live Performance In genart
404.zero - ARRIVAL
2020
ntu S1 AY2526 | DM3008 | Generative art
WEEK 4 | Live Performance In genart
Ryoji ikeda - live at sonar
2010
ntu S1 AY2526 | DM3008 | Generative art
WEEK 4 | Live Performance In genart
Ryoji ikeda - test pattern
2013
ntu S1 AY2526 | DM3008 | Generative art
WEEK 4 | Live Performance In genart
rhizomatiKs x Elevenplay
2017



ntu S1 AY2526 | DM3008 | Generative art
WEEK 4 | Live Performance In genart
rhizomatiKs x Elevenplay
2017
ntu S1 AY2526 | DM3008 | Generative art
WEEK 4 | Live Performance In genart
Louis-philippe demers & Bill Vorn - inferno
2016

ntu S1 AY2526 | DM3008 | Generative art
WEEK 4 | Live Performance In genart
Louis-philippe demers & Bill Vorn - inferno
2016
ntu S1 AY2526 | DM3008 | Generative art
WEEK 4 | Live Performance In genart
NONOTAK
2020

ntu S1 AY2526 | DM3008 | Generative art
WEEK 4 | Live Performance In genart
marshmallow laser feast - we live in an ocean of air
2018

ntu S1 AY2526 | DM3008 | Generative art
WEEK 4 | Live Performance In genart
marshmallow laser feast - we live in an ocean of air
2018
ntu S1 AY2526 | DM3008 | Generative art
WEEK 4 | Live Performance In genart
Robert henke - CBM 8032 AV
2020
ntu S1 AY2526 | DM3008 | Generative art
WEEK 4 | Live Performance In genart
Robert henke - phosphor
2020
ntu S1 AY2526 | DM3008 | Generative art
WEEK 4 | Live Performance In genart
Alexandra Cárdenas and Olivia Jack @ ICLC
2019
ntu S1 AY2526 | DM3008 | Generative art
WEEK 4 | Live Performance In genart
Francesco Corvi - Live Coding Performance
2023
ntu S1 AY2526 | DM3008 | Generative art
WEEK 4 | Live Performance In genart
natural intelligence in art
4
INTELLIGENCE
the ability to learn, understand, and make judgments or have opinions that are based on reason
ntu S1 AY2526 | DM3008 | Generative art
WEEK 4 | NATURAL INTELLIGENCE In art
INTELLIGENCE
1 : the ability to learn or understand or to deal with new or trying situations.
2 : the ability to apply knowledge to manipulate one's environment or to think abstractly as measured by objective criteria (such as tests)
ntu S1 AY2526 | DM3008 | Generative art
WEEK 4 | NATURAL INTELLIGENCE In art
BIOART
It was not until in 1997 artist Eduardo KAC coined the term “bio art” in his performance work, Time Capsule, that theorists and critics started to use it to refer to art practices in which artists work with “live tissues, bacteria, living organisms, and life processes.”
ntu S1 AY2526 | DM3008 | Generative art
WEEK 4 | NATURAL INTELLIGENCE In art
BIOART
In the book, Signs of Life: Bio Art and Beyond, KAC explained:
Bio art is a new direction in contemporary art that manipulates the processes of life. Invariably, bio art employs one or more of the following approaches:
(1) The coaching of biomaterials into specific inert shapes or behaviors;
(2) the unusual or subversive use of biotech tools and processes;
(3) the invention or transformation of living organisms with or without social or environmental integration
ntu S1 AY2526 | DM3008 | Generative art
WEEK 4 | NATURAL INTELLIGENCE In art
Eduardo kac - Genesis
1999

ntu S1 AY2526 | DM3008 | Generative art
WEEK 4 | NATURAL INTELLIGENCE In art
This gene was created by translating a sentence from the biblical book of Genesis into Morse Code, and converting the Morse Code into DNA base pairs according to a conversion principle specially developed for this work. The sentence reads: "Let man have dominion over the fish of the sea, and over the fowl of the air, and over every living thing that moves upon the earth."
ntu S1 AY2526 | DM3008 | Generative art
WEEK 4 | NATURAL INTELLIGENCE In art
Paul Vanouse


ntu S1 AY2526 | DM3008 | Generative art
WEEK 4 | NATURAL INTELLIGENCE In art
Paul Vanouse, Latent Figure Protocol (2007-2010)
ntu S1 AY2526 | DM3008 | Generative art
WEEK 4 | NATURAL INTELLIGENCE In art



a media installation that uses DNA samples to create emergent representational images.
joe davis - bacterial radio
2012

ntu S1 AY2526 | DM3008 | Generative art
WEEK 4 | NATURAL INTELLIGENCE In art
a crystal radio system that uses a protein derived from marine sponges to create an electrical circuit capable of receiving AM radio transmissions
Adam Brown - Origins of Life: Experiment #1.4
2010

ntu S1 AY2526 | DM3008 | Generative art
WEEK 4 | NATURAL INTELLIGENCE In art
Scientists such as Haldane and Oparin in the 1920s and ‘30s proposed that life evolved over great periods of time through a series of stages that produced first simple organic molecules, then more complex ones, then self-catalytic ones, and finally organized modules from which the first cells could emerge.
Sarah grant - in collaboration with Selena Savic, as part of the Thinking Toys for Commoning research project

ntu S1 AY2526 | DM3008 | Generative art
WEEK 4 | NATURAL INTELLIGENCE In art
Sarah grant - in collaboration with Selena Savic, as part of the Thinking Toys for Commoning research project

ntu S1 AY2526 | DM3008 | Generative art
WEEK 4 | NATURAL INTELLIGENCE In art
After exploring outward evenly, the slime mold decides to head toward the object of higher mass and wider mass distribution.
“Cognition is all around you. It really is everywhere,” says Levin. “And really, it’s not just for furry, brainy things.”
[harvard magazine]
ntu S1 AY2526 | DM3008 | Generative art
WEEK 4 | NATURAL INTELLIGENCE In art
ecoLogicStudio - XenoDerma

ntu S1 AY2526 | DM3008 | Generative art
WEEK 4 | NATURAL INTELLIGENCE In art
Špela Petrič - Phytoteratology
2019

ntu S1 AY2526 | DM3008 | Generative art
WEEK 4 | NATURAL INTELLIGENCE In art
Špela Petrič - Phytoteratology
2019



ntu S1 AY2526 | DM3008 | Generative art
WEEK 4 | NATURAL INTELLIGENCE In art
A molecular performance in which plant embryos are grown in artificial wombs in lieu of seeds. Baby plants are nourished with hormones extracted from the artist’s urine. Thus plant-human hybrids (phytopolutans) are bred
amy karle - regenerative reliquary
2015-2016

ntu S1 AY2526 | DM3008 | Generative art
WEEK 4 | NATURAL INTELLIGENCE In art
Bioprinted scaffold that disintegrates over time, with the intention of human stemcells seeded onto the design.
amy karle - regenerative reliquary
2015-2016
ntu S1 AY2526 | DM3008 | Generative art
WEEK 4 | NATURAL INTELLIGENCE In art
heather barnett - the physarum experiments
2008
ntu S1 AY2526 | DM3008 | Generative art
WEEK 4 | NATURAL INTELLIGENCE In art
ntu S1 AY2526 | DM3008 | Generative art
WEEK 4 | NATURAL INTELLIGENCE In art
Since 2008 Heather Barnett has been working with the true slime mould, Physarum polycephalum, observing and influencing its growth patterns, navigational abilities and seemingly human behaviours. Used as a model organism in diverse scientific studies, the single cell organism is attributed with a primitive form of intelligence, problem solving skills and the ability to anticipate events...
...The organism is a nomadic information system. As it creeps across its terrain it makes continuous micro-decisions about surrounding atmospheric conditions and resource distribution. With no brain or sensory organs, this amorphous cellular mass computes the complexities of its environment through chemical signalling. It is a highly adaptive biological barometer.
Daria Fedorova - Artists full body imprint. Nutrient, spores, 2 weeks of incubation
2021

ntu S1 AY2526 | DM3008 | Generative art
WEEK 4 | NATURAL INTELLIGENCE In art
The artist laces petri dishes with various bacterias and other organisms before placing extra elements like sugars, and sprinkles in the container.

philip beesley - Hylozoic Ground
2010
ntu S1 AY2526 | DM3008 | Generative art
WEEK 4 | NATURAL INTELLIGENCE In art
Helen Pynor and Peta Clancy - The Body is a Big Place
2011

ntu S1 AY2526 | DM3008 | Generative art
WEEK 4 | NATURAL INTELLIGENCE In art
As part of the installation a fully functioning heart perfusion system is used to reanimate to a beating state a pair of fresh pig hearts during a live performance.
chelsea manning - radical love
2016


ntu S1 AY2526 | DM3008 | Generative art
WEEK 4 | NATURAL INTELLIGENCE In art
Radical Love is an homage and exploration of gender identity stereotypes in forensic DNA phenotyping. The full color life-sized 3d printed portraits of Chelsea Manning were generated from analyses of her DNA, extracted from cheek swabs and hair clippings sent to the artist from Chelsea through the mail while she was in prison.
Individual Presentations
‣ Read the brief [link]
‣ Present a deep dive of one or two artworks by an artist from the list.
‣ Outline the generative concept of the work, artistic process and technology involved.
‣ At the end, close off by stating how it interests you.
Preparing for your presentations (Sept 22)
ntu S1 AY2526 | DM3008 | Generative art
WEEK 4 | NATURAL INTELLIGENCE In art
FOR WEEK 5
‣ Select an artist to present on.
‣ Inform Jo your chosen artist by the end of class or via email by the end of the week.
‣ Start preparing your presentations for September 22 (Week 7)
Preparing for your presentations
FOR WEEK 5
‣ Select an artist to present on.
‣ Inform Jo your chosen artist by the end of class or via email by the end of the week.
‣ Start preparing your presentations for September 22 (Week 7)
Preparing for your presentations
AI IN ART
5
ntu S1 AY2526 | DM3008 | Generative art
WEEK 5 | AI In art

ntu S1 AY2526 | DM3008 | Generative art
WEEK 5 | AI In art
the myth of Talos
Unlike Galatea, whose “realism became reality supernaturally,” Talos was not merely created “by magic spells or divine fiat,” writes Mayor. He was said to be engineered by Hephaestus, or rather “made, not born,” in a process the ancients “might have called biotechne, from bios ‘life’ and techne, ‘crafted through art or science.’
Talos was depicted in myth as a machine programmed to act human though never capable of achieving regular human life—what one might call a robot today.
[Smithsonian Magazine]

ntu S1 AY2526 | DM3008 | Generative art
WEEK 5 | AI In art


ntu S1 AY2526 | DM3008 | Generative art
WEEK 5 | AI In art
Paracelsus and Homunculus in ‘De Natura Rerum’ (1537)
Artificial life has been a topic of discussion long before the advent of cloning. Greek legends, such as Cadmus’ dragon’s teeth soldiers and Pygmalion’s living statue, are just some of the earlier examples of this concept. During the Renaissance Period, the homunculus, an artificial human, came to the fore in alchemist’s writings. The Swiss physician/alchemist Paracelsus (1493/1494–1541 CE) contributed to the rise in prominence of the being.
[C.S. VOLL ON MEDIUM]


ntu S1 AY2526 | DM3008 | Generative art
WEEK 5 | AI In art

ntu S1 AY2526 | DM3008 | Generative art
WEEK 5 | AI In art
ON MARY SHELLEY'S FRANKENSTEIN (1818)
The narrative of Victor Frankenstein's relentless pursuit of creating life, only to be haunted by the unforeseen horrors of his creation, has resonated across generations. This tale of hubris, moral dilemmas, and the intricate relationships between creator and creation continues to transcend time, finding a striking resonance in contemporary discussions on AI and its potential implications. The research article endeavors to delve into the parallels between AI and "Frankenstein," unraveling the profound ethical dilemmas faced by AI developers, policymakers, and society at large.
[SSRN]

ntu S1 AY2526 | DM3008 | Generative art
WEEK 5 | AI In art

ntu S1 AY2526 | DM3008 | Generative art
WEEK 5 | AI In art
computing machinery and intelligence (1950)
I propose to consider the question, ' Can machines think ? ' ... The new form of the problem can be described in terms of a game which we call the 'imitation game '. The new form of the problem can be described in terms of a game which we call the 'imitation game '. It is played with three people, a man (A), a woman (B), and an interrogator (C) who may be of either sex. The interrogator stays in a room apart from the other two. The object of the game for the interrogator is to determine which of the other two is the man and which is the woman... We now ask the question, ' What will happen when a machine takes the part of A in this game ? '
[A. M. Turing]

ntu S1 AY2526 | DM3008 | Generative art
WEEK 5 | AI In art
What is ai?
What are some examples?
ntu S1 AY2526 | DM3008 | Generative art
WEEK 5 | AI In art
ntu S1 AY2024 | DM3008 | Generative art





WEEK 4 | AI IN ART




ntu S1 AY2526 | DM3008 | Generative art
WEEK 5 | AI In art
Artificial intelligence
artificial intelligence (AI), the ability of a digital computer or computer-controlled robot to perform tasks commonly associated with intelligent beings. The term is frequently applied to the project of developing systems endowed with the intellectual processes characteristic of humans, such as the ability to reason, discover meaning, generalize, or learn from past experience.
[Britannica]
ntu S1 AY2526 | DM3008 | Generative art
WEEK 5 | AI In art

Subsets of AI
ntu S1 AY2526 | DM3008 | Generative art
WEEK 5 | AI In art
How do we learn what an apple is?

ntu S1 AY2526 | DM3008 | Generative art
WEEK 5 | AI In art
Dataset
A dataset in machine learning and artificial intelligence refers to a collection of data that is used to train and test algorithms and models. These datasets are crucial to the development and success of machine learning and AI systems, as they provide the necessary input and output data for the algorithms to learn from.
ntu S1 AY2526 | DM3008 | Generative art
WEEK 5 | AI In art

Datasets are the key to training a model
ntu S1 AY2526 | DM3008 | Generative art
WEEK 5 | AI In art
Latent space
In AI, latent space can be defined as a multidimensional vector space that represents the learned characteristics of a set of data. This abstract space encapsulates the essential features and attributes of the input data, fostering the development of efficient AI models.
ntu S1 AY2526 | DM3008 | Generative art
WEEK 5 | AI In art
Latent Space
ntu S1 AY2526 | DM3008 | Generative art
WEEK 5 | AI In art

ntu S1 AY2526 | DM3008 | Generative art
WEEK 5 | AI In art
Generative adversarial networks (GAN)

ntu S1 AY2526 | DM3008 | Generative art
WEEK 5 | AI In art
Diffusion models (i.e. stable diffusion)
REFIK ANADOL - Machine Hallucinations
MoMA, 2022 - 2024
ntu S1 AY2526 | DM3008 | Generative art
WEEK 5 | AI In art
REFIK ANADOL - LATENT BEING
kraftwerk berlin, 2019
ntu S1 AY2526 | DM3008 | Generative art
WEEK 5 | AI In art



ntu S1 AY2526 | DM3008 | Generative art
WEEK 5 | AI In art
Andy Gracie and Brian Lee Yung Rowe - Autoinducer_Ph-1
2013

ntu S1 AY2526 | DM3008 | Generative art
WEEK 5 | AI In art
Andy Gracie and Brian Lee Yung Rowe - Autoinducer_Ph-1
2013
ntu S1 AY2526 | DM3008 | Generative art
WEEK 5 | AI In art
Sofia Crespo - Neutral zoo
2018 - 2020

ntu S1 AY2526 | DM3008 | Generative art
WEEK 5 | AI In art
Sofia Crespo - ‘{{floral automata_1236}}’
2018 - 2020

ntu S1 AY2526 | DM3008 | Generative art
WEEK 5 | AI In art
Sougwen Chung - Sougwen Chung, Drawing with D.O.U.G. Performance
2016
ntu S1 AY2526 | DM3008 | Generative art
WEEK 5 | AI In art
ntu S1 AY2526 | DM3008 | Generative art
WEEK 5 | AI In art
Sougwen Chung




ntu S1 AY2526 | DM3008 | Generative art
WEEK 5 | AI In art
HOLLY HERNDON - SPAWN
2020
ntu S1 AY2526 | DM3008 | Generative art
WEEK 5 | AI In art
ntu S1 AY2526 | DM3008 | Generative art
WEEK 5 | AI In art
HOLLY HERNDON



ntu S1 AY2526 | DM3008 | Generative art
WEEK 5 | AI In art
Sarah meyohas - cloud of petals
2017




ntu S1 AY2526 | DM3008 | Generative art
WEEK 5 | AI In art
Sarah meyohas - cloud of petals
2017
ntu S1 AY2526 | DM3008 | Generative art
WEEK 5 | AI In art
Proof of Personhood
2024

ntu S1 AY2526 | DM3008 | Generative art
WEEK 5 | AI In art
Christopher Kulendran Thomas - Being Human
2019/2022

ntu S1 AY2526 | DM3008 | Generative art
WEEK 5 | AI In art
Christopher Kulendran Thomas - Being Human
2019/2022

ntu S1 AY2526 | DM3008 | Generative art
WEEK 5 | AI In art
Christopher Kulendran Thomas - Being Human
2019/2022

ntu S1 AY2526 | DM3008 | Generative art
WEEK 5 | AI In art
jo+kapi - simulacra
2023


ntu S1 AY2526 | DM3008 | Generative art
WEEK 5 | AI In art

Jo Ho - Skelchion #1
2022


ntu S1 AY2526 | DM3008 | Generative art
WEEK 5 | AI In art
Jo Ho - Skelchion Drafts
2022




ntu S1 AY2526 | DM3008 | Generative art
WEEK 5 | AI In art
ntu S1 AY2526 | DM3008 | Generative art
WEEK 5 | AI In art

ntu S1 AY2526 | DM3008 | Generative art
WEEK 5 | AI In art

By the end of 2025, De Vries-Gao estimates, energy consumption by AI systems could approach up to 49% of total datacentre power consumption, again excluding crypto mining. AI consumption could reach 23 gigawatts (GW), the research estimates, twice the total energy consumption of the Netherlands.
[The Guardian]
ntu S1 AY2526 | DM3008 | Generative art
WEEK 5 | AI In art

ntu S1 AY2526 | DM3008 | Generative art
WEEK 5 | AI In art
ntu S1 AY2526 | DM3008 | Generative art
WEEK 5 | AI In art
DISCUSSION ON lecture
15 min
Some questions to think about:
‣ What is a topic in AI in Art that interests you? Share it with the overall group afterwards. Prompt us with a question.
‣ What is your stance on AI Art? Is it "real" art? Why or why not?
‣ What are some precautions we need to make when using AI in Art?
Review today's lecture on artificial intelligence in art, and reflect in groups
ntu S1 AY2526 | DM3008 | Generative art
WEEK 3 | Coding In art
Gen:48 competition by runway
ntu S1 AY2526 | DM3008 | Generative art
WEEK 5 | AI In art
Exercise 3a
‣ Pick a movie of your choosing. It may be anything from live action to animated.
‣ Look up (3) still shots from this movie
‣ Write (1) prompts for each of them, and generate images from Text to Image in Runway ML.
Using Runway ML's tools to create images
ntu S1 AY2526 | DM3008 | Generative art
WEEK 4 | NATURAL INTELLIGENCE In art
ntu S1 AY2526 | DM3008 | Generative art
WEEK 4 | NATURAL INTELLIGENCE In art

Exercise 3a
Using Runway ML's tools to create images
ntu S1 AY2526 | DM3008 | Generative art
WEEK 4 | NATURAL INTELLIGENCE In art


Exercise 3a
Using Runway ML's tools to create images
ntu S1 AY2526 | DM3008 | Generative art
WEEK 4 | NATURAL INTELLIGENCE In art


Exercise 3a
Using Runway ML's tools to create images
ntu S1 AY2526 | DM3008 | Generative art
WEEK 4 | NATURAL INTELLIGENCE In art



Exercise 3a
Using Runway ML's tools to create images
ntu S1 AY2526 | DM3008 | Generative art
WEEK 4 | NATURAL INTELLIGENCE In art

Describe the scene
Objects (Shape? Material? Orientation? Action?)
Landscape (Foreground / Background)
Atmosphere (Dusty? Foggy? Clear?)
Color grading (Monochromatic? Low or high saturation?)
Exercise 3a
Example image prompt
ntu S1 AY2526 | DM3008 | Generative art
WEEK 4 | NATURAL INTELLIGENCE In art

One huge floating spaceship in the distance hovering above a vast expanse of desert. Void of all life except for three figures floating downwards where there are 7 more figures on the ground. The air is orange and dusty. The scene is dark, moody and made of shades of orange.
Exercise 3a
Example image prompt
‣ Save your generated images or use frame as input for video.
‣ Generate videos with each of these images. Use your imagination. Describe your shot before you generate the video.
Using Runway ML's tools to create a short video
ntu S1 AY2526 | DM3008 | Generative art
WEEK 4 | NATURAL INTELLIGENCE In art

Exercise 3B
‣ Some directions you can take with your video:
‣ A faithful recreation.
‣ Starts as a faithful recreation, but develops into something else
‣ A completely different rendition
‣ Image generations are altered,
video generations are experimental
Using Runway ML's tools to create a short video
ntu S1 AY2526 | DM3008 | Generative art
WEEK 4 | NATURAL INTELLIGENCE In art
Exercise 3B
‣ Tips:
‣ Stylistically, do all the video clips
match? Do they have to?
‣ How do they tell a story, if any?
‣ What is the intent of the entire video,
if any?
Using Runway ML's tools to create a short video
ntu S1 AY2526 | DM3008 | Generative art
WEEK 4 | NATURAL INTELLIGENCE In art
Exercise 3B
Don't forget about the various other tools
ntu S1 AY2526 | DM3008 | Generative art
WEEK 4 | NATURAL INTELLIGENCE In art
Exercise 3B

‣ Use a video editor to edit the video clips together. You may use any you wish.
‣ Here are some free ones:
Veed / Adobe Express / Capcut
‣ Once completed, upload it onto our class
Edit the videos together into one clip
ntu S1 AY2526 | DM3008 | Generative art
WEEK 4 | NATURAL INTELLIGENCE In art
Exercise 3C
FOR WEEK 6
‣ If you haven't informed Jo of the artist you have selected please do so ASAP.
‣ Keep working on your presentations for September 22 (Week 7)
Keep working on your presentations
Creating with Generative art
6
Phase 1
Phase 2
Phase 3
Phase 5
- Ideas
- Questions
- Sketching
- Brainstorming
- Planning
- Testing
- Iterating
- Decision making
1 minute to a few years to a lifetime
Conceptualization
Planning
Installation
Experimentation
Phase 4
- Putting the project together
- Troubleshooting
- Building parts
- Preparing for installation
Preparation
- Setting up
- On-site adjustments
- Last minute purchasing
- Troubleshooting
~ 1 week - 2 weeks
3-5 weeks
1-3 weeks
2-3 days
Creating an Artwork
A suggested guideline
ntu S1 AY2526 | DM3008 | Generative art
WEEK 6 | Creating with Generative Art
my desire to consume (exhibit name)
2022

ntu S1 AY2526 | DM3008 | Generative art
WEEK 6 | Creating with Generative Art
ENZYME 1.0 presented at grey projects
2022

ntu S1 AY2526 | DM3008 | Generative art
WEEK 6 | Creating with Generative Art
ENZYME 1.0 presented at grey projects
2022


ntu S1 AY2526 | DM3008 | Generative art
WEEK 6 | Creating with Generative Art
ENZYME 1.0 presented at grey projects
2022

ntu S1 AY2526 | DM3008 | Generative art
WEEK 6 | Creating with Generative Art
PHASE 1
Conceptualization
ntu S1 AY2526 | DM3008 | Generative art
WEEK 6 | Creating with Generative Art

ntu S1 AY2526 | DM3008 | Generative art
WEEK 6 | Creating with Generative Art

ntu S1 AY2526 | DM3008 | Generative art
WEEK 6 | Creating with Generative Art

ntu S1 AY2526 | DM3008 | Generative art
WEEK 6 | Creating with Generative Art
Personal questions about NFTs
What is the value of digital artwork?
Why are people purchasing these images?
What is the point of these images?
Is the value of the artwork just about its potential value in the market?
ntu S1 AY2526 | DM3008 | Generative art
WEEK 6 | Creating with Generative Art

ntu S1 AY2526 | DM3008 | Generative art
WEEK 6 | Creating with Generative Art
Initial conceptualization (2021)

ntu S1 AY2526 | DM3008 | Generative art
WEEK 6 | Creating with Generative Art
Initial conceptualization (2021)

ntu S1 AY2526 | DM3008 | Generative art
WEEK 6 | Creating with Generative Art
Initial conceptualization (2021)
PHASE 2
Planning
ntu S1 AY2526 | DM3008 | Generative art
WEEK 6 | Creating with Generative Art
ntu S1 AY2526 | DM3008 | Generative art
WEEK 6 | Creating with Generative Art

Presentation and participation grant by NAC

ntu S1 AY2526 | DM3008 | Generative art
WEEK 6 | Creating with Generative Art
Grey Projects at tiong bahru

ntu S1 AY2526 | DM3008 | Generative art
WEEK 6 | Creating with Generative Art
Grey Projects at tiong bahru

ntu S1 AY2526 | DM3008 | Generative art
WEEK 6 | Creating with Generative Art
Brief for artist collaborators

ntu S1 AY2526 | DM3008 | Generative art
WEEK 6 | Creating with Generative Art
Brief for artist collaborators

ntu S1 AY2526 | DM3008 | Generative art
WEEK 6 | Creating with Generative Art
Brief for artist collaborators

ntu S1 AY2526 | DM3008 | Generative art
WEEK 6 | Creating with Generative Art
Brief for artist collaborators

ntu S1 AY2526 | DM3008 | Generative art
WEEK 6 | Creating with Generative Art
Brief for artist collaborators

ntu S1 AY2526 | DM3008 | Generative art
WEEK 6 | Creating with Generative Art
Brief for artist collaborators

ntu S1 AY2526 | DM3008 | Generative art
WEEK 6 | Creating with Generative Art
Brief for artist collaborators

ntu S1 AY2526 | DM3008 | Generative art
WEEK 6 | Creating with Generative Art
Brief for artist collaborators
PHASE 3
Experimentation
ntu S1 AY2526 | DM3008 | Generative art
WEEK 6 | Creating with Generative Art



ntu S1 AY2526 | DM3008 | Generative art
WEEK 6 | Creating with Generative Art
Initial looks at digesting aesthetics

Conway's game of life
1970
ntu S1 AY2526 | DM3008 | Generative art
WEEK 6 | Creating with Generative Art
Conway's game of life
1970


ntu S1 AY2526 | DM3008 | Generative art
WEEK 6 | Creating with Generative Art

ntu S1 AY2526 | DM3008 | Generative art
WEEK 6 | Creating with Generative Art
Marketing and pamphlets




ntu S1 AY2526 | DM3008 | Generative art
WEEK 6 | Creating with Generative Art
submissions from artist collaborators
PHASE 4
Preparation
ntu S1 AY2526 | DM3008 | Generative art
WEEK 6 | Creating with Generative Art

ntu S1 AY2526 | DM3008 | Generative art
WEEK 6 | Creating with Generative Art
setup plan



ntu S1 AY2526 | DM3008 | Generative art
WEEK 6 | Creating with Generative Art
renting and purchasing new equipment




ntu S1 AY2526 | DM3008 | Generative art
WEEK 6 | Creating with Generative Art
renting and purchasing new equipment
PHASE 5
Installation
ntu S1 AY2526 | DM3008 | Generative art
WEEK 6 | Creating with Generative Art
ntu S1 AY2526 | DM3008 | Generative art
WEEK 6 | Creating with Generative Art


ntu S1 AY2526 | DM3008 | Generative art
WEEK 6 | Creating with Generative Art
setting up screens and wall text

ntu S1 AY2526 | DM3008 | Generative art
WEEK 6 | Creating with Generative Art
all set up, after sculpting wires and loading artworks in
ntu S1 AY2526 | DM3008 | Generative art
WEEK 6 | Creating with Generative Art
enzyme 1.0 at Grey projects (2022)
Sharing interests
10 min
‣ Write 2 words from each category (see next slide) you're most interested in.
‣ One word per post-it note. Write your name on each one, at the bottom right.
‣ Place your post-it notes on the board
‣ As a group, cluster similar or related words together. Where do we see common ground? Which clusters feel exciting to you? Spot potential collaborators.
Let's find our overlaps and connections in interests
ntu S1 AY2526 | DM3008 | Generative art
WEEK 6 | Creating with Generative Art
Sharing interests
ntu S1 AY2526 | DM3008 | Generative art
WEEK 6 | Creating with Generative Art
Characteristics of GenArt | Elements | Disciplines | Hard/software | Aesthetics |
---|---|---|---|---|
Randomly generated Unpredictable Using uncertainty Unrepeatable Unique Varying outcomes Autonomous systems Process-driven Geometric/abstract Procedural Systematic Artists set the rules Recipes Time, environment, human and computational processes Building relationships Made by rules, results change Interaction with viewers |
Datasets Iterations Algorithms Repetition Randomness Automation Controlled Chaos Interactivity Commentary Autonomous Algorithms Visuals Rules Time |
Game design Manual/analog Line art Robotics Visual Art Sonic art/Music Computer Science Engineering Math Sciences Graphic Design Architecture Painting Projection Mapping Installation Image-making Video Art |
Hardware Computers 3D Printers Digital Screens Projector Robots Cameras Mics Sensors Speakers Environment Nature Paint Traditional Media Cameras Software P5js TouchDesigner Unity |
Animated Minimalistic Humor Abstract Interactivity Natural Geometric Data-driven Painting Games, programming Point clouds Experimental Surrealism Organic Avatars |
Group brainstorm
10 min
‣ We will group up with different people each time (see next slide) to brainstorm three different project pitches.
‣ Brainstorm for 10 minutes.
‣ Give an elevator pitch to the class.
Let's group up and pitch our ideas to the class
ntu S1 AY2526 | DM3008 | Generative art
WEEK 6 | Creating with Generative Art
Group brainstorm
ntu S1 AY2526 | DM3008 | Generative art
WEEK 6 | Creating with Generative Art
Group | Part 1 | Part 2 | Part 3 |
---|---|---|---|
A | Avril Dora Jinyao Hayley |
Dora Rohin Jakub Samuel |
Jinyao Jaslyn Yumeng Samuel |
B | Garren Rohin Janis Jaslyn |
Avril Garren Yumeng Taehoon |
Dora Janis Wardah Taehoon |
C | Yumeng Jakub Natalie Wardah |
Jinyao Janis Natalie Caroline |
Avril Rohin Natalie Zhang Yin |
D | Taehoon Samuel Caroline Zhang Yin |
Hayley Jaslyn Wardah Zhang Yin |
Hayley Garren Jakub Caroline |
PART 1
Projection Mapping Project
ntu S1 AY2526 | DM3008 | Generative art
WEEK 6 | Creating with Generative Art

National Gallery Singapore has asked you to create a projection mapping project for their facade.
‣ What type of concept would you create?
‣ What kind of graphics would you make?
‣ What programs would you use?
You're allowed to use sketches, storyboarding, or slides
10 min
PART 2
Screen-based Project
ntu S1 AY2526 | DM3008 | Generative art
WEEK 6 | Creating with Generative Art
You're allowed to use sketches, storyboarding, or slides
10 min

You have a series of coding outcomes.
‣ How would you display them using screens?
‣ How are the screens laid out? What sizes are they?
PART 3
Immersive Project
ntu S1 AY2526 | DM3008 | Generative art
WEEK 6 | Creating with Generative Art
You're allowed to use sketches, storyboarding, or slides
You are provided an immersive room of all four walls.
‣ What will you immerse your viewers with?
‣ Is it interactive?
‣ What is the concept or story behind it?

10 min
FOR WEEK 7
Finish your presentations for 22 September. We will follow the order down below. Max. 8 mins for presentations, 2 mins for feedback. 10 min break between 8th and 9th presentation.
# | Name | Artist Chosen |
---|---|---|
1 | Janis | Rhizomatiks |
2 | Garren | Raven Kwok |
3 | Taehoon | Philip Beesley |
4 | Yin Zhang | 404.zero |
5 | Hayley | Sofia Crespo |
6 | Samuel | Manfred Mohr |
7 | Rohin | Refik Anadol |
8 | Dora | Nonotak |
# | Name | Artist Chosen |
---|---|---|
9 | Yumeng | Heather Barnett |
10 | Jinyao | |
11 | Natalie | Jenna Sutela |
12 | Wardah | Casey Reas |
13 | Jaslyn | David O'Reilly |
14 | Avril | Zach Lieberman |
15 | Caroline | E.A.T. |
16 | Jakub | Eduardo KAC |
FOR WEEK 8
Select your team members
Individual Presentations
7
WEEK 7 PRESENTATIONS
We will follow the order down below. Max. 8 mins for presentations, 2 mins for feedback. 10 min break between 8th and 9th presentation.
# | Name | Artist Chosen |
---|---|---|
1 | Janis | Rhizomatiks |
2 | Garren | Raven Kwok |
3 | Taehoon | Philip Beesley |
4 | Yin Zhang | 404.zero |
5 | Hayley | Sofia Crespo |
6 | Samuel | Manfred Mohr |
7 | Rohin | Refik Anadol |
8 | Dora | Nonotak |
# | Name | Artist Chosen |
---|---|---|
9 | Yumeng | Heather Barnett |
10 | Jinyao | |
11 | Natalie | Jenna Sutela |
12 | Wardah | Casey Reas |
13 | Jaslyn | David O'Reilly |
14 | Avril | Zach Lieberman |
15 | Caroline | E.A.T. |
16 | Jakub | Eduardo KAC |
FOR WEEK 8
Select your team members
TouchDesigner Workshop 1
8
WEEK 8 PRESENTATIONS
We continue with the presentations we haven't seen yet. Max. 8 mins for presentations, 1 min for feedback.
# | Name | Artist Chosen |
---|---|---|
1 | Dora | Nonotak |
2 | Jaslyn | David O'Reilly |
3 | Avril | Zach Lieberman |
4 | Caroline | E.A.T. |
5 | Jakub | Eduardo KAC |
WEEK 8 | TouchDesigner workshop 1
ntu S1 AY2526 | DM3008 | Generative art
Touchdesigner
ntu S1 AY2526 | DM3008 | Generative art

WEEK 8 | TouchDesigner workshop 1
Exercise 4
ntu S1 AY2526 | DM3008 | Generative art
WEEK 8 | TouchDesigner workshop 1

FOR WEEK 9
Select your team members
TouchDesigner Workshop 2
9
FINAL GROUPS
These will be the groups you will be in for the last three weeks of class for your Final Group Project.
Group | 1 | 2 | 3 | 4 |
---|---|---|---|---|
Jaslyn Garren Samuel Jakub (Kuba) |
Hayley Janis Jinyao Yumeng |
Avril Natalie Wardah Taehoon |
Dora Rohin Caroline Zhang Yin |
WEEK 8 | TouchDesigner workshop 1
ntu S1 AY2526 | DM3008 | Generative art
Touchdesigner
ntu S1 AY2526 | DM3008 | Generative art

WEEK 8 | TouchDesigner workshop 1
EXERCISE 5
ntu S1 AY2526 | DM3008 | Generative art
WEEK 8 | TouchDesigner workshop 1

FOR WEEK 10
‣ Review the Final Project brief (NTU Learn).
‣ Next Monday is a holiday. We will instead be taking online consultations that week Tuesday - Friday to share your first project concepts.
‣ One person from each group select a meeting time on this form by 11:30 pm October 20th.
Start brainstorming project concepts with your groups
DM3008 Generative Art AY2526 Sem1
By Joanne Ho
DM3008 Generative Art AY2526 Sem1
- 317